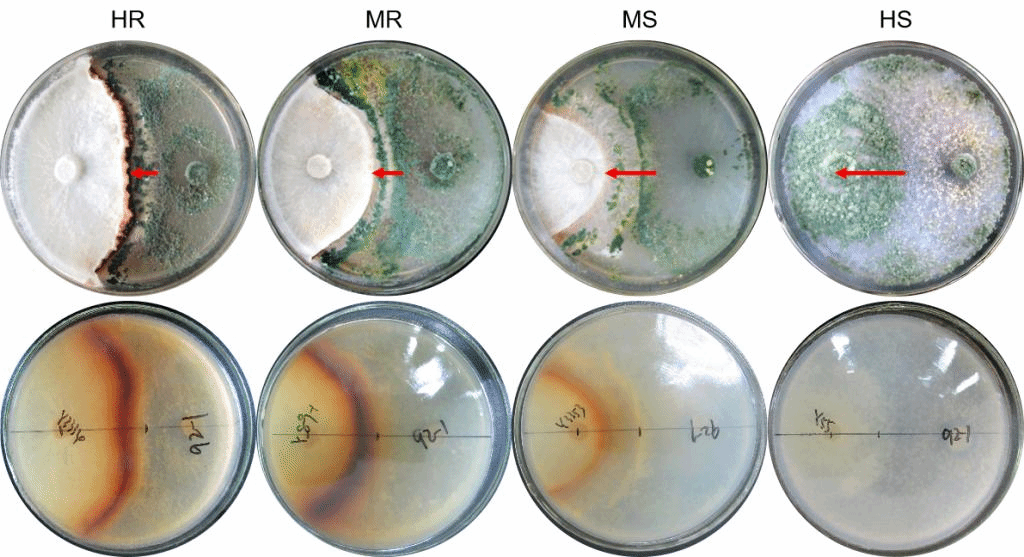
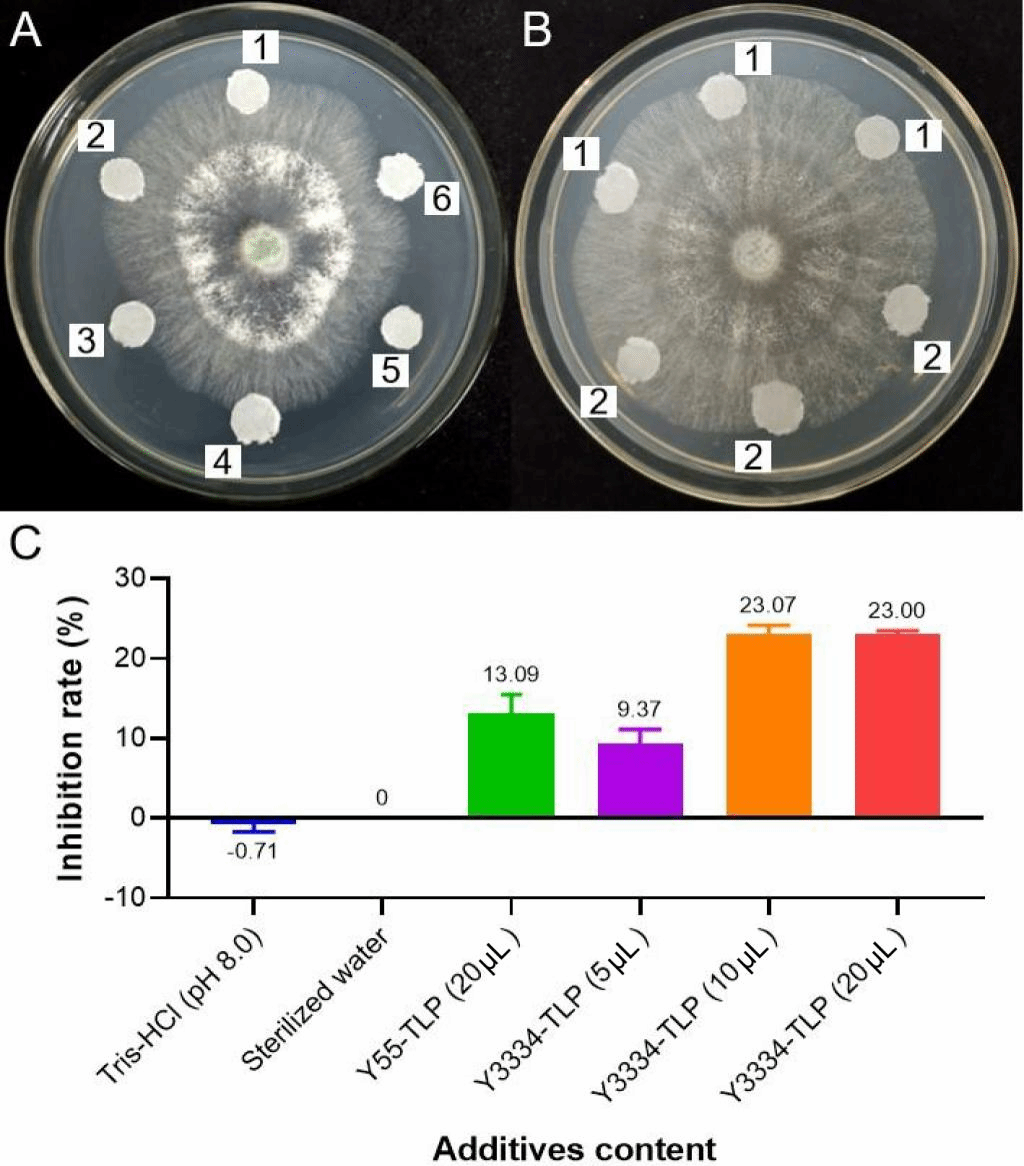

(通讯员:马晓龙)香菇料袋或菌棒感染木霉菌(Trichoderma spp.)是导致香菇大幅度减产,影响产业效益的主要因素之一。近期,应用真菌团队以“Enhanced Expression of Thaumatin-like Protein Gene (LeTLP1) Endows Resistance to Trichoderma atroviride in Lentinula edodes”为题,在学术期刊life在线发表了团队在香菇抗深绿木霉分子机制方面取得的重要成果。
团队开展了香菇种质资源群体抗深绿木霉性状鉴定评价,建立了香菇对深绿木霉的抗性鉴定模型,筛选出重要的抗性鉴定模式材料。采用比较转录组学方法,筛选出香菇在抵抗深绿木霉侵染过程中起重要作用的类甜蛋白基因LeTLP1,发现LeTLP1仅在香菇菌丝受深绿木霉侵染后大量表达,LeTLP1基因表达丰度与香菇的深绿木霉抗性正相关。原核表达验证了重组LeTLP1蛋白具有抗真菌活性,且氨基酸位点变异显著影响其活性。
图1 香菇与深绿木霉互作的4种模型

图2 LeTLP1基因过表达和沉默表达对香菇抗深绿木霉侵染的影响
图3 外源添加LeTLP1重组蛋白对深绿木霉菌丝生长的影响
该成果是近年来食用菌抗木霉分子机制研究的重要突破,为香菇抗病育种研究奠定了坚实基础。博士生马晓龙为本文第一作者,边银丙教授为本文通讯作者。该研究得到国家食用菌产业技术体系和国家重点研发计划支持。
审核人:边银丙
论文链接://www.mdpi.com/2075-1729/11/8/863


